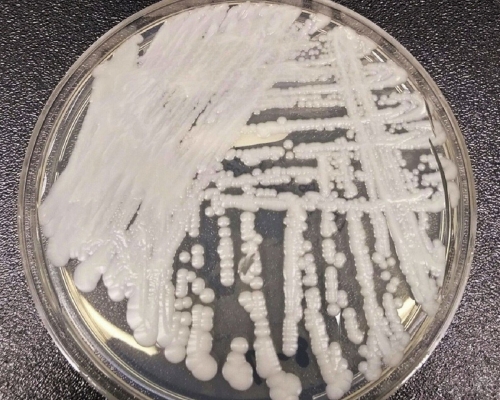
美國疾病控制與預防中心(CDC)一個實驗室在培養皿中培養出的「耳念珠菌」(Candida auris)。AP

超級細菌攻入中國最少18人確診 致命率高達60%
更新時間:00:37 2019-04-10 HKT
發佈時間:17:14 2019-04-09 HKT
發佈時間:17:14 2019-04-09 HKT
美國出現一種高抗藥性超級真菌「耳念珠菌」,致死率高達60%,當地已列入緊急威脅名單。為超級真菌已經攻入中國,中國工程院院士、第二軍醫大學長征醫院皮膚科教授廖萬清表示,「截至目前,中國已確認18宗超級真菌臨床感染病例。我們還在持續監測,但總體上還沒有出現美國那樣的爆發性流行感染。」
紐約市西奈山醫院去年5月為一名老年男子做腹部手術時,發現他感染了一種「神秘而致命」的真菌,醫院迅速將其隔離在重症監護室。該男子最終在住院90天后死亡,但這種致命的真菌卻頑強地存活下來。病房很多地方都遭到了入侵,院方為此對牆壁、病床、門、水槽、電話都進行了特殊消毒,甚至拆除了部分天花板和地板。目前耳念珠菌的多重耐藥真菌在紐約、新澤西和伊利諾伊等12個州流行。
北京大學醫學部檢驗學系主任、北京大學人民醫院檢驗科主任王輝指,「超級真菌能長時間存活於患者和醫護人員的皮膚及醫院設施表面,若感染控制措施不力,容易導致院內爆發性感染。」2018年在英國爆發的超級真菌感染,其罪魁禍首就是一隻共用的體溫計。
廖萬清解釋,「從現有文獻看,感染者大多會有原因不明的發高燒,各種藥物治療無效,並伴隨各種器官衰竭、呼吸衰竭等表現。」2018年,中國發現首宗耳念珠菌臨床感染病例。自此內地共確認18例耳念珠菌臨床感染病例,還在持續監測。
耳念珠菌的來源目前還不明確,是環境真菌還是人體共生菌,也不清楚。研究人員普遍認為,這是新近進化出來的、快速適應人體宿主環境能力的新物種,主要引起血液感染,致死率高達60%。
在顯微鏡下,耳念珠菌與其他念珠菌並無明顯差異,但通常具有多重耐藥性,部分菌株對臨床上常用的三大類抗真菌藥物都具有很高的耐藥性。這種超級真菌對免疫系統不成熟或受損的人最致命,包括初生兒和老年人、吸煙人群、糖尿病患者以及自身免疫性疾病患者。
紐約市西奈山醫院去年5月為一名老年男子做腹部手術時,發現他感染了一種「神秘而致命」的真菌,醫院迅速將其隔離在重症監護室。該男子最終在住院90天后死亡,但這種致命的真菌卻頑強地存活下來。病房很多地方都遭到了入侵,院方為此對牆壁、病床、門、水槽、電話都進行了特殊消毒,甚至拆除了部分天花板和地板。目前耳念珠菌的多重耐藥真菌在紐約、新澤西和伊利諾伊等12個州流行。
北京大學醫學部檢驗學系主任、北京大學人民醫院檢驗科主任王輝指,「超級真菌能長時間存活於患者和醫護人員的皮膚及醫院設施表面,若感染控制措施不力,容易導致院內爆發性感染。」2018年在英國爆發的超級真菌感染,其罪魁禍首就是一隻共用的體溫計。
廖萬清解釋,「從現有文獻看,感染者大多會有原因不明的發高燒,各種藥物治療無效,並伴隨各種器官衰竭、呼吸衰竭等表現。」2018年,中國發現首宗耳念珠菌臨床感染病例。自此內地共確認18例耳念珠菌臨床感染病例,還在持續監測。
耳念珠菌的來源目前還不明確,是環境真菌還是人體共生菌,也不清楚。研究人員普遍認為,這是新近進化出來的、快速適應人體宿主環境能力的新物種,主要引起血液感染,致死率高達60%。
在顯微鏡下,耳念珠菌與其他念珠菌並無明顯差異,但通常具有多重耐藥性,部分菌株對臨床上常用的三大類抗真菌藥物都具有很高的耐藥性。這種超級真菌對免疫系統不成熟或受損的人最致命,包括初生兒和老年人、吸煙人群、糖尿病患者以及自身免疫性疾病患者。





























